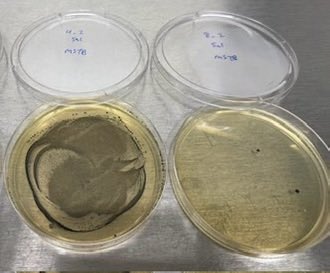
<a href="/thegarybrecka/">Gary Brecka</a> You can also use our biotech nano lipid toothpaste to directly remove P. Gingivalis which is the main cause of VSC ( volatile sulfur compounds) aka bad breath ! We also select for S. Mutans which causes cavities. I reduced mine by 99.9% in 8 days!

greg
@gregc9
Product Management Leader /former @EsportsEng, CBSSports, natgeo, weather channel/ Esports, comics, tech, sports, AS Roma, Italia, Mets, Rangers,Giants moviesTV
ID: 22638814
03-03-2009 16:06:45
26,26K Tweet
1,1K Followers
3,3K Following

Repost to help me make my first Pro Bowl. Thanks for the support! #ProBowlVote Andrew Thomas



Gary Brecka You can also use our biotech nano lipid toothpaste to directly remove P. Gingivalis which is the main cause of VSC ( volatile sulfur compounds) aka bad breath ! We also select for S. Mutans which causes cavities. I reduced mine by 99.9% in 8 days!

In Case You Missed It (spelled it out so you know I’m serious) Connor Rogers & I launched our early position ranking series on NFL Stock Exchange with wide receivers Our top 12 receivers for the 2026 class with full breakdowns for each Guy 📺⬇️ youtube.com/live/boxIurNXx…















